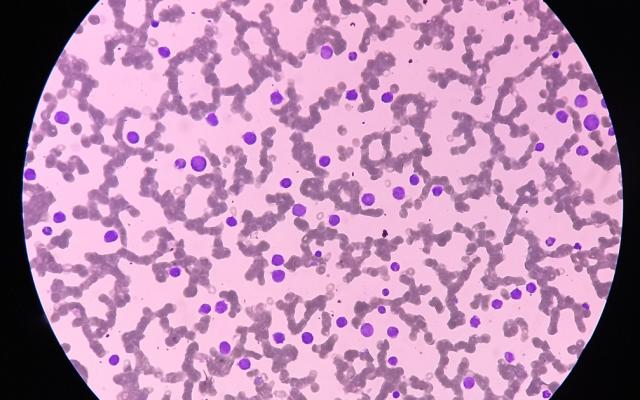
Microscopisch beeld

Beste collega’s,
In deze klinische les gaan we het hebben over onbedoeld gewichtsverlies. Dat kan een alarmsymptoom zijn voor een onderliggende maligniteit, maar dat is het niet altijd. Wanneer zou de huisarts een patiënt met onbedoeld gewichtsverlies moeten verwijzen, en wanneer is het verantwoord om af te wachten?
Onbedoeld gewichtsverlies geldt als mogelijk alarmsymptoom voor een onderliggende maligniteit. Met een maligniteit in de differentiaaldiagnose zal de huisarts laagdrempelig aanvullende diagnostiek verrichten of de patiënt naar de tweede lijn verwijzen. Het zou helpen als andere risicofactoren of gegevens in de anamnese, het lichamelijk onderzoek of het aanvullend onderzoek bijdragen aan de beslissing om snel door te verwijzen voor diagnostiek of juist het beloop af te wachten. In deze klinische les beschrijven wij drie patiënten die werden geanalyseerd voor gewichtsverlies. Aan de hand van deze patiënten en op basis van recente literatuur geven we aanbevelingen wanneer doorverwijzen wenselijk is of een afwachtend beleid mogelijk lijkt.
Patiënt A, een 59-jarige man die bekend is met heroïne- en cocaïne-abusus, en matig COPD met fors bulleus emfyseem, werd door de huisarts verwezen wegens onverklaard gewichtsverlies. De patiënt had circa 15 kg aan gewicht verloren. Met oriënterend bloedonderzoek had de huisarts een licht verhoogde…

Reacties